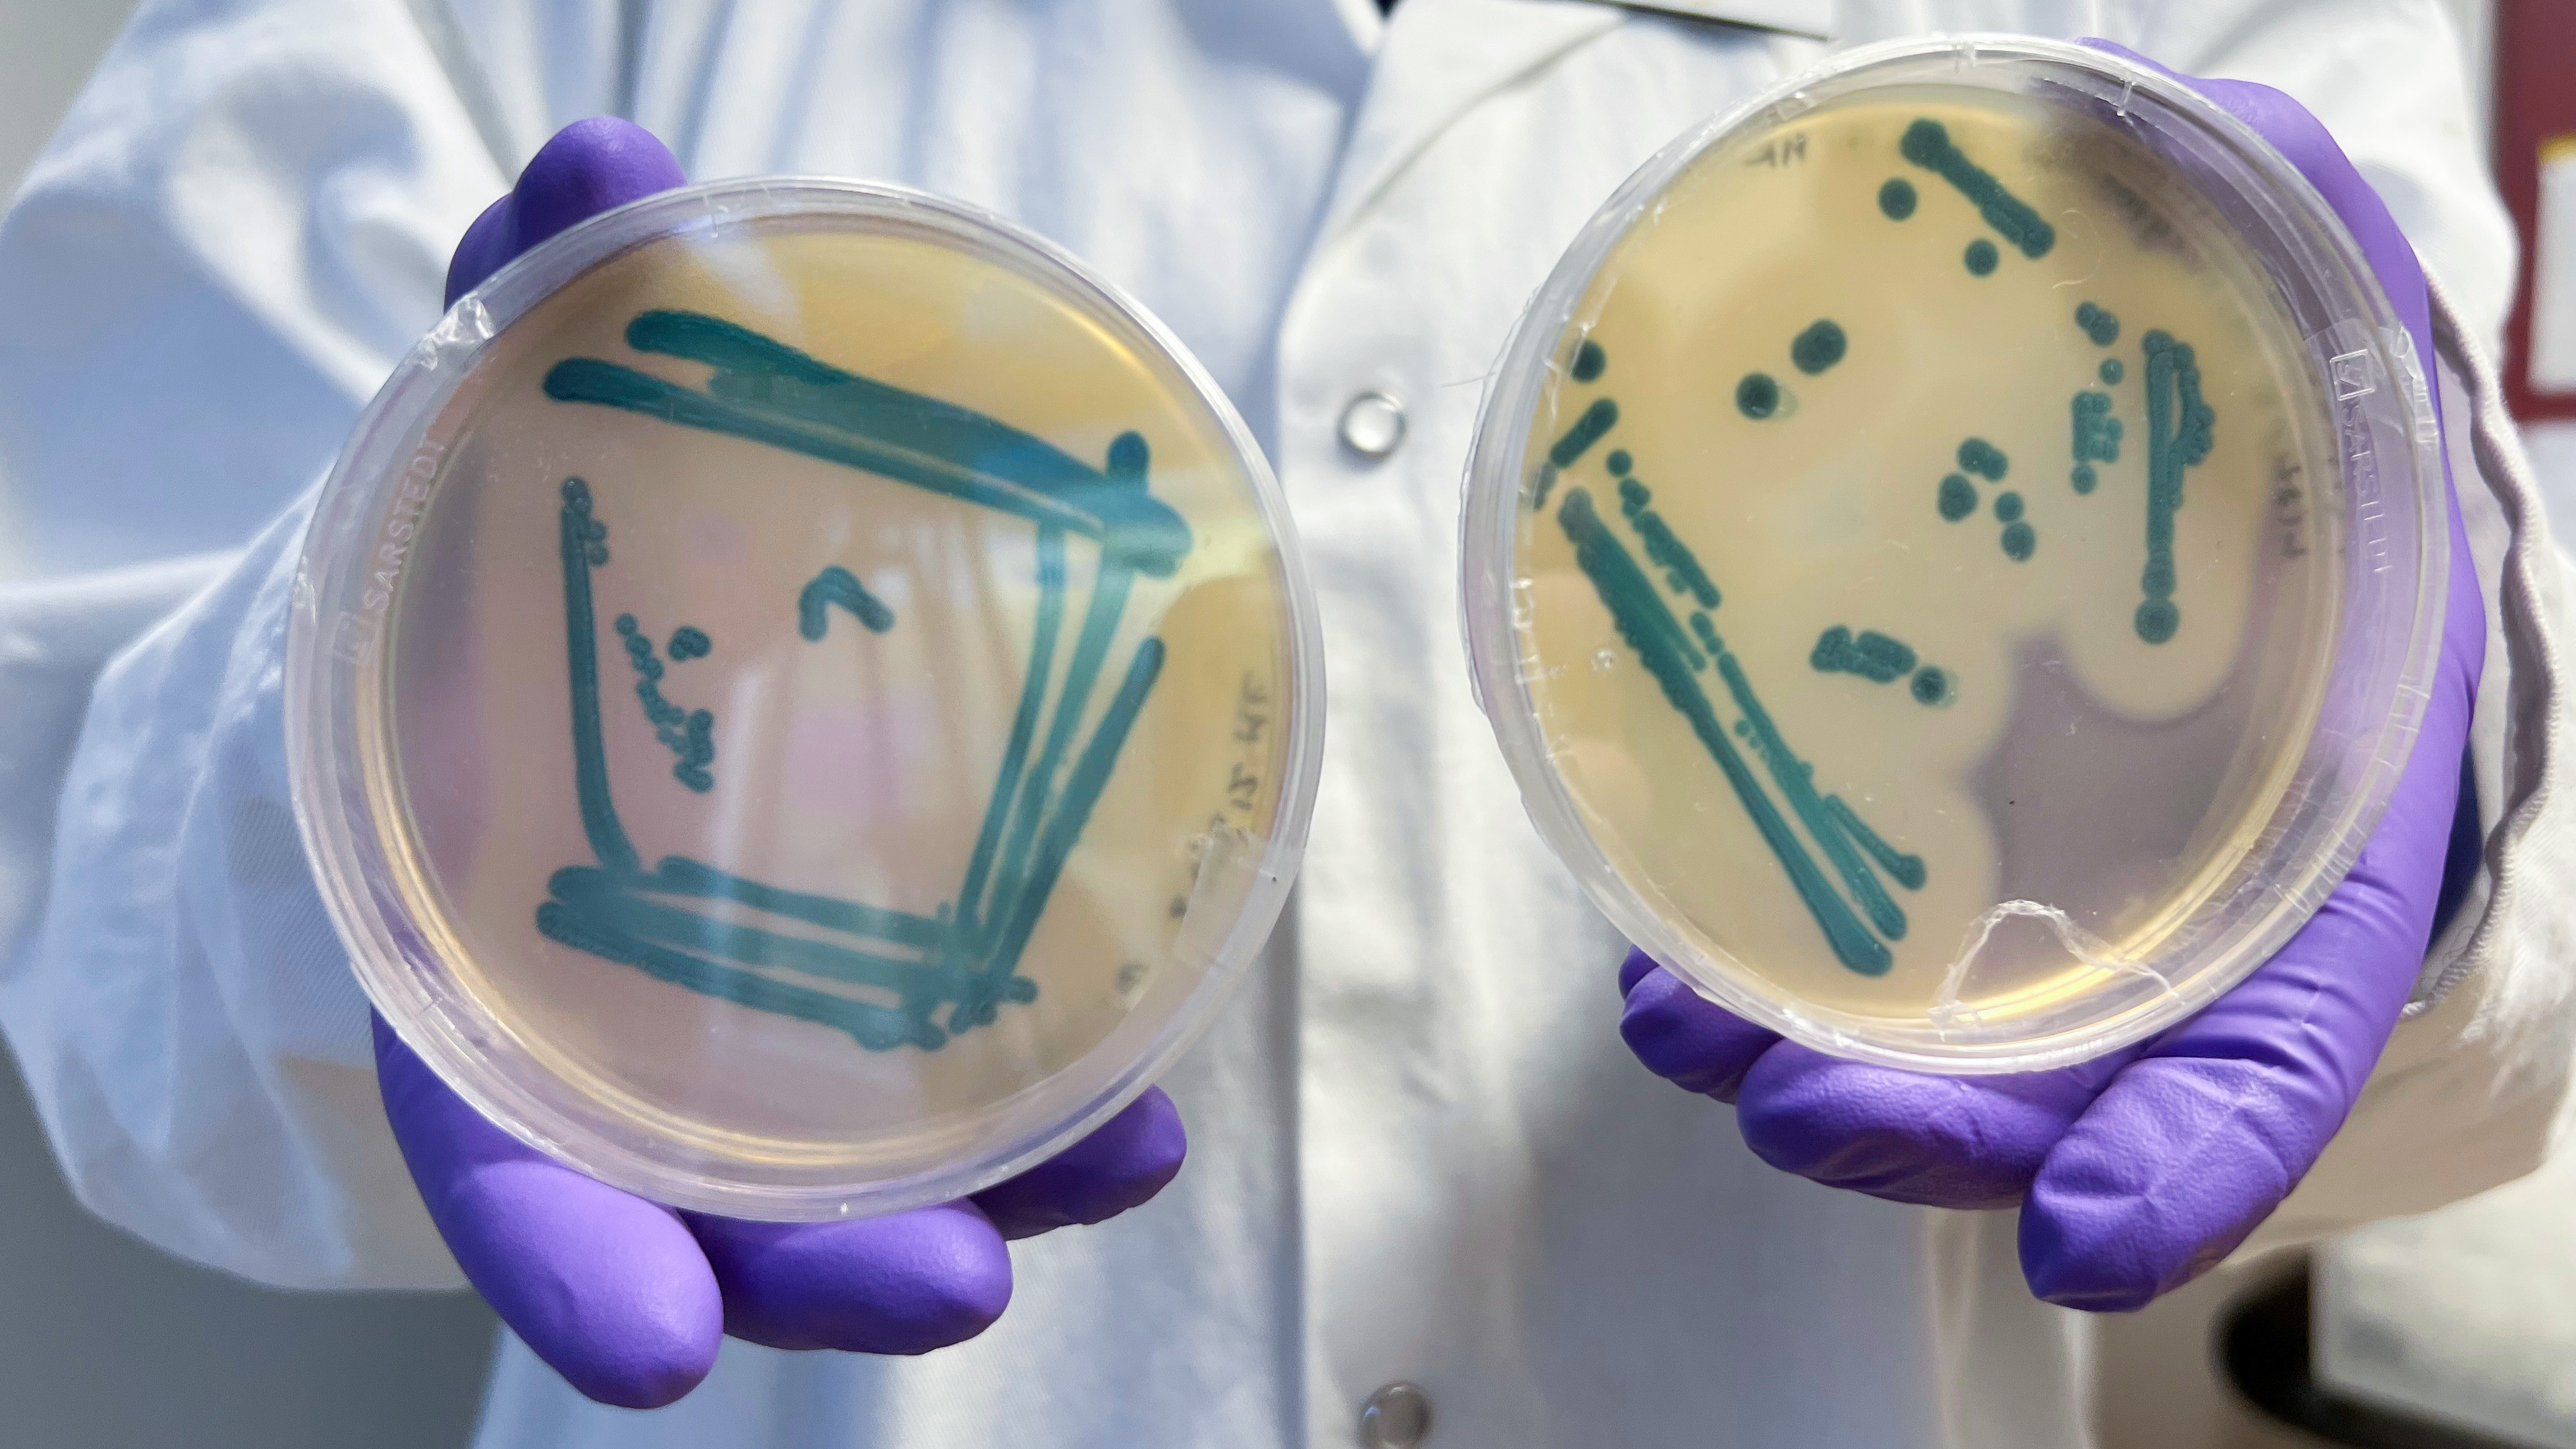
Petri dishes with growth is demonstrated

Forskningskommunikation @LTV
The team at Science Communication @LTV provides support to the research staff at the LTV-Faculty. We work strategically and operationally on communication to enhance the impact of research.
Science Communication @LTV works internally to strengthen our collective communication competence and find synergies in collaboration, but we also work externally to highlight research and its outcomes.
How can you benefit from our assistance?
We provide advisory services in communication and welcome inquiries for coaching ahead of project applications or support in designing communication plans.
The team also undertakes direct communication efforts, such as writing articles, producing short interview films, and assisting with press contacts.
Feel free to reach out to our shared mailbox or contact us directly. Contact information is provided below.
Tools and tips for employees at the Staff web.